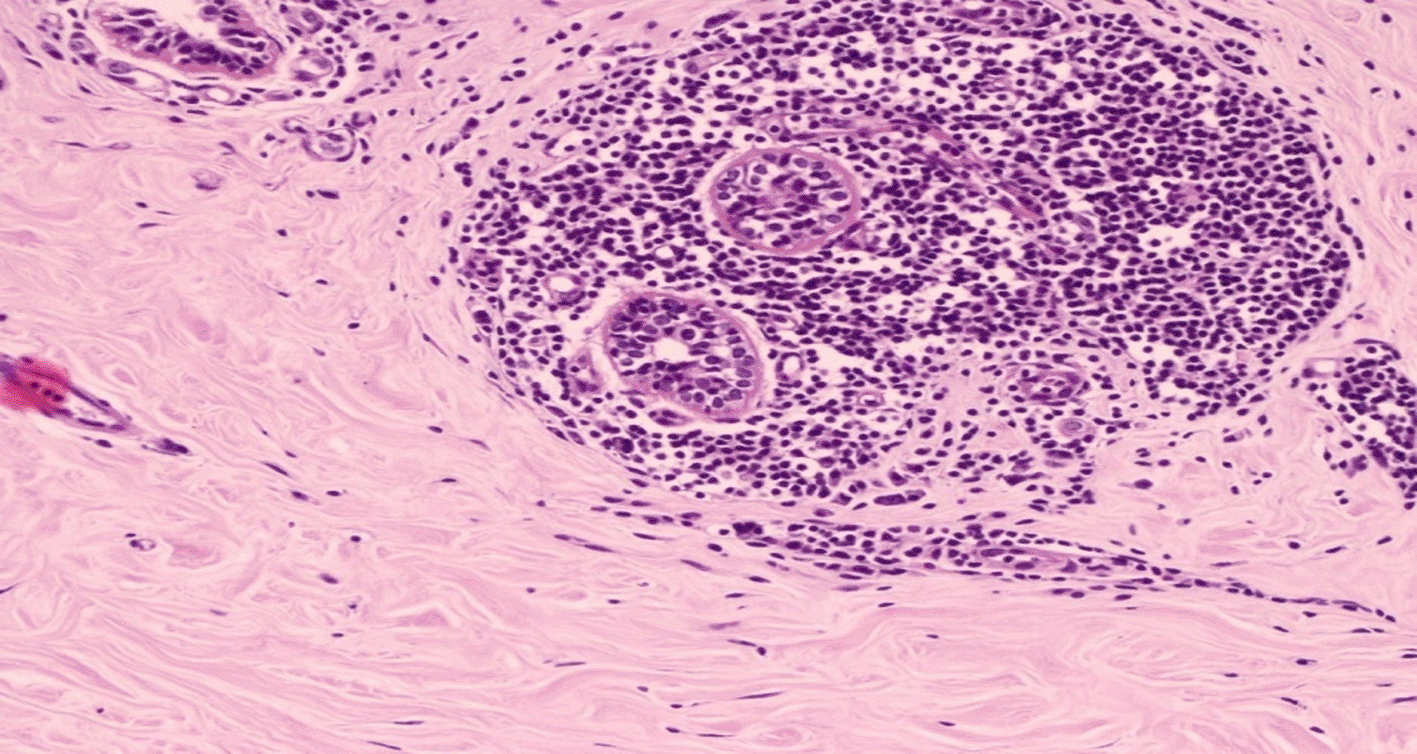

Keywords
Sclerosing lymphocytic lobulitis, type I diabetes, complication, microbiopsy
Sclerosing lymphocytic lobulitis, also known as diabetic mastopathy, is a rare and benign pathology predominantly observed in young women with type I diabetes, typically with degenerative complications. Clinically, the lesion can mimic carcinoma. Biopsy remains the gold standard for a definitive diagnosis. Radical surgery is generally unnecessary when histological verification can be achievedusing core needle biopsy. This case report details the clinical and radiological findings, as well as the management of a 33-year-old patient with a 22-year history of type I diabetes who presented with sclerosing lymphocytic lobulitis.
Sclerosing lymphocytic lobulitis, type I diabetes, complication, microbiopsy
It has long been believed that the mammary gland is not affected by degenerative complications of diabetes. This was thought to be true until 1984, when Soler and Khardorifirst described a case of mammary lesions associated with type I diabetes.1 Sclerosing lymphocytic lobulitis (SCLL) is a rare and benign tumor that accounts for less than 1% of all benign breast lesions.2 SCLL mostly occurs in women with type I diabetes at the stage of degenerative complications. However, cases of SCLL have also been described in patients with type II diabetes, autoimmune diseases such as Hashimoto’s thyroiditis, as well as in healthy individuals and in men.3 It sets a diagnostic trap since it mimics clinically a breast carcinoma.4 We present a case of SCLL occurring in a patient with type I diabetes for 22 years, detailing the associated clinical, radiological, and evolutionary aspects, along with the particularities of its management.
Our patient was a 33-year-old nulliparous woman without a family history of breast cancer, who presented with swelling in her right breast. She was diagnosed with type I diabetes 22 years ago and was administered a high insulin dose. Her diabetes was at the stage of degenerative complications, with hypertension for three years, managed with an angiotensin-converting enzyme inhibitor, and stage III retinopathy. The glycosylated hemoglobin level was 8.2%.
The patient was referred to us for consultation with a right-sided breast tumor. On inspection, asymmetry of the two breasts was noted, with an increased right breast size. On palpation, a 5 cm retroareolar tumor on the right side was identified, characterized by stony consistency and slight mobility with respect to the deeper layers, without signs of inflammation or palpable lymph nodes. No particular mention was made of the left breast.
Breast ultrasound revealed a heterogeneous retroareolar hypoechoic formation on the right, measuring 5 × 3 cm, with irregular contours and attenuation of posterior echoes (Figure 1).

It revealed a right heterogeneous retroareolarhypoechoic, not well-limited formation of irregular contours of 5 × 3 cm in size with attenuation of the posterior echoes.
A microbiopsy was performed, concluding that SCLL is a pathological finding with intralobular, periductal, and perivascular nodular lymphocyte infiltrations associated with marked lobular atrophy and extensive interlobular hyaline fibrosis (Figure 2).
(HE X400): High-power photomicrograph of a hematoxylin and eosin-stained section of a breast biopsy specimen showingintralobular lymphocytic infiltration.
Given the poorly controlled diabetes, the risk of mutilating surgery (small overall breast volume) and high risk of recurrence, annual clinic, and radiological monitoring werechosen. The patient has been monitored regularly since 2019, and there has been no increase in tumor size or changes in the breast ultrasound findings.
SCLL or diabetic mastopathy are rare and benign pathological entity.1 The prevalence of this disease is unknown becauseof poor knowledge of the condition. The incidence of SCLLranges from 0.6% to 13%.1,5 According to Hunfeld and Bassler,6 SCLL accounts for less than 1% of all benign breast lesions. This percentage increased to 13% when considering only patients with type I diabetes.6
This condition mainly affects young women with type I diabetes, frequently at the stage of degenerative complications.7,8 Similar anatomical lesions have been less frequently described in other autoimmune pathologies (such as thyroiditis and lupus) and in patients with type II diabetes requiring insulin.3 The occurrence in men is exceptional; five cases have been reported in men.9,10
Several physiopathological factors have been identified; notably, hyperglycemiaisbelieved to be responsible for abnormal accumulation and decreased connective tissue degradation in the extracellular matrix.11
• The specific toxicity of exogenous insulin explains the appearance of this condition in type II diabetes after the use of insulin.12
• An autoimmune process secondary to excess glycosylation in the extracellular matrix, thus forming neoantigens. This causesan autoimmune reaction against these neoantigens with lymphocytic infiltration, predominantly of B cells and macrophages. The presence of cytokines accentuatescollagenization.4,10–13
Clinically, SCLL typically presents as one or multiple unilateral or bilateral breast nodules with recent onset. These nodules had irregular contours, were hard or even stony in consistency, and were painless. They often grow rapidly and are mobile with respect to both superficial and deeper layers.3 It is frequently retroareolar and measures from 0.5 to 6cm in size.3 It was not associated with nipple discharge or inflammatory skin phenomena. Our patient presented with a stony retroareolar nodule that was poorly circumscribed, measured 5 cm, and suspected malignant.
These lesions clinically mimic those of breast cancer. Therefore, the use of complementary examinations or surgery is essential.
Mammography frequently shows overdensities, more or less regular opacities, and even dense breasts, but without architectural distortion or calcific foci.12–15 However, mammography remains difficult to interpret because of the young age of patients and the density ofbreast tissue.
Ultrasound, on the other hand, is more concerning, as the lesion often appears as a hypoechoic formation with irregular contours and strong ultrasound attenuation, which are characteristics frequently observed in polymitotic processes.15 Among the signs suggestive of malignancy, posterior acoustic shadowing and indistinct margins.16 Ultrasonographic abnormalities were observed in our patient.
Contrast-enhanced MRI may be indicativeof doubts regarding the diagnosis of malignant lesion.3 SCLL lesions present a homogeneously low enhancement with a gradual and progressive course and subsequent contrast wash-out seen on MRI imaging.17
Fine-needle aspiration is difficult to achieve becauseof the sclerotic nature of the lesion. Williams et al8 and Logan5 report an uninterpretable aspiration rate of 50% due to the poverty of cellular elements.
Biopsy is therefore the examination of choice, which establishes the diagnosis.16Fine-needle biopsy is not recommended due to increased fibrosis. Coreneedle biopsy is the gold standard.14 Histological study revealed three types of elementary, non-specific associated lesions16: lymphocytic lobulitis: mononuclear inflammatory infiltration, more or less dense, associatedwithsmall B lymphocytes, plasma cells, and histiocytes. It is found mainly in the mammary lobulesand less markedly in the perivascular spaces and sometimes in the periductalspaces.
• Fibrosis of intralobular connective tissue is always found, homogeneous, and dense.
• Inconsistently, stromal epithelioid cells are homogeneously distributed.
There are two types of lymphocytic lobulitis (LL): SCLL and non-sclerosing LL (NSCLL).18 The two types of LL are distinguished by stromal features and a predominant population of B-cells in the former and T-cells in the latter.18
Immunohistochemistry is only of interest to exclude the differential diagnosis of infiltrating lobular carcinoma (anti-keratin antibody) in cases where epithelioid cells are particularly numerous4,11
• low-grade non-Hodgkin’s lymphomas when lymphoid infiltration appears suspicious.7
Conservative management can be considered when a histological diagnosis has been confirmed through a core-needle biopsy.2
In cases in which a conservative approach is chosen, it is crucial to educate the patient on proper breast self-examination techniques. A schedule for regular follow-up visits should be established, and an annual mammography is recommended.19
For cases involving a single lesion, surgical excision with an adequate margin of normal breast tissue remains the primary treatment option, particularly when no definitive histological diagnosis has been made, if the core biopsy findings are inconclusive, or if the patient has significant concerns regarding the breast lump.20
A literature review indicated that 90% of the patients underwent excisional biopsy.2 The reasons cited included patient requests, anxiety, insufficient findings on fine-needle aspiration, the necessity to definitively rule out breast carcinoma, and clinician unfamiliarity with this condition.2
Wider margins during excision may help decrease the recurrence rate.21
Despite treatment, a high recurrence rate (30–60% within 5 years) has been reported, with recurrences often affecting a wider region than the initial lesion.22 Bilateral and contralateral recurrences have also been documented.22 Most patients with recurrence undergo re-excision; however, this should be avoided in patients with a history of SCLL.2 In cases of multiple or recurrent lesions, once the diagnosis is established, subcutaneous mastectomy can be considered, especially for patients with multiple symptomatic lesions and small breasts, to avoid significant distortions from lumpectomy.23
Each diagnosed case of SCLL should be individually managed. The type of surgery (mastectomy with immediate reconstruction or lumpectomy) should be carefully planned to ensure the best quality of life and optimal aesthetic outcomes.3 The surgical treatment plan should also consider the tumor and breast size, number of lesions, patient expectations, family history, and experience of the surgical team.3
SCLL is a rare and benign disease associated with degenerative complications in women with type I diabetes. It is a diagnostic trap because it can clinically imitate breast carcinoma. Histological examination of the microbiopsies is sufficient to establish the diagnosis, thus avoiding mutilating surgery in these young diabetics.
Written informed consent for publication of their clinical details and images was obtained from the patient on January 2024.
KhaoulaMagdoud: Conception, manuscript drafting, final approval.sirine Bayar: Conception, manuscript drafting, and final approval. Nejlaarifi: manuscript drafting andfinal approval. Sana Menjli: manuscript drafting andfinal approval. Rim Ben Hmid:conception, manuscript drafting, and final approval
No data are associated with this article.
Reporting guidelines
This work has been reported in line with the SCARE 2023 criteria. 24
Harvard Dataverse: CARE checklist for “Sclerosing lymphocytic lobulitis of the breast: case report and literature review” doi.org/10.7910/DVN/50LCHP. 25
Data are available under the terms of the Creative Commons Zero “No rights reserved” data waiver (CC0 1.0 Public domain dedication).
| Views | Downloads | |
|---|---|---|
| F1000Research | - | - |
|
PubMed Central
Data from PMC are received and updated monthly.
|
- | - |
Is the background of the case’s history and progression described in sufficient detail?
Yes
Are enough details provided of any physical examination and diagnostic tests, treatment given and outcomes?
Partly
Is sufficient discussion included of the importance of the findings and their relevance to future understanding of disease processes, diagnosis or treatment?
Yes
Is the case presented with sufficient detail to be useful for other practitioners?
Yes
Competing Interests: No competing interests were disclosed.
Reviewer Expertise: Breast Oncosurgeon
Is the background of the case’s history and progression described in sufficient detail?
Partly
Are enough details provided of any physical examination and diagnostic tests, treatment given and outcomes?
Yes
Is sufficient discussion included of the importance of the findings and their relevance to future understanding of disease processes, diagnosis or treatment?
Yes
Is the case presented with sufficient detail to be useful for other practitioners?
Partly
Competing Interests: No competing interests were disclosed.
Reviewer Expertise: Breast Imaging and Interventions
Alongside their report, reviewers assign a status to the article:
| Invited Reviewers | ||
|---|---|---|
| 1 | 2 | |
|
Version 2 (revision) 22 Aug 25 |
||
|
Version 1 27 Aug 24 |
read | read |
Provide sufficient details of any financial or non-financial competing interests to enable users to assess whether your comments might lead a reasonable person to question your impartiality. Consider the following examples, but note that this is not an exhaustive list:
Sign up for content alerts and receive a weekly or monthly email with all newly published articles
Already registered? Sign in
The email address should be the one you originally registered with F1000.
You registered with F1000 via Google, so we cannot reset your password.
To sign in, please click here.
If you still need help with your Google account password, please click here.
You registered with F1000 via Facebook, so we cannot reset your password.
To sign in, please click here.
If you still need help with your Facebook account password, please click here.
If your email address is registered with us, we will email you instructions to reset your password.
If you think you should have received this email but it has not arrived, please check your spam filters and/or contact for further assistance.
Comments on this article Comments (0)